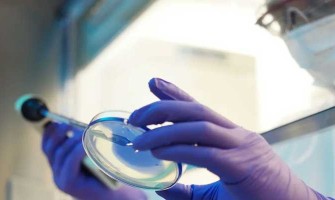
Clinical Study: Changes in 40-65 Age Group After 60 Days of NMN Use Clinical Study: Changes in 40-65 Age Group After 60 Days of NMN Use

0
608
Brain’s “Stress Guardian”: How the CB1 Receptor Offers New Hope Against DepressionIn the microscopic world of the brain, a protein called cannabinoid ..
0
678
In the world of anti-cancer foods, sulforaphane is hailed as a "super antioxidant" and is highly praised by health experts and nutritionists. Not only..
0
658
Skeleton muscles are a type of muscle tissue composed of skeletal muscle cells. Most skeletal muscles are attached to bones and are the most abundant ..
0
599
Age is the most important independent risk factor influencing the prevalence of chronic diseases in the elderly. Today, let's explore the preventive e..
0
704
NMN shows great potential in the prevention and improvement of cardiovascular and cerebrovascular diseases through mechanisms such as improving endoth..
0
940
Japanese researchers have discovered that NMN supplementation can mitigate age-related auditory decline in mice, offering a promising avenue for the p..
0
754
Luteolin is a naturally occurring flavonoid compound that typically appears as pale yellow, needle-like crystals. It often exists in glycosylated form..
0
986
A new study has shown that NMN significantly improves mitochondrial function and energy metabolism in the ovaries of aging mice, reduces ovarian infla..
0
4071
As people become more health-conscious and seek to extend their lifespan, the scientific community has intensified its research into anti-aging compou..
0
746
Apigenin, a naturally occurring flavonoid, is found abundantly in various fruits, vegetables, and herbs. In recent years, it has gained significant at..
0
2468
While antioxidants are a familiar term, true understanding of their role often remains limited. They are widely believed to hold the secret to prevent..
0
930
Shilajit is a black, sticky substance primarily secreted from the rocks of the Himalayas. Its Sanskrit name, शिलाजतु, translates to "conqueror of rock..
0
577
Attention Deficit Hyperactivity Disorder (ADHD) is a condition affecting millions worldwide, characterized by symptoms such as inattention, hyperactiv..
0
716
A newly published study, combining a literature review and a survey of U.S. college students, concludes that medical marijuana may be an effective too..
0
801
Atherosclerosis is a common cardiovascular disease characterised by thickening and stiffening of the arterial wall, loss of elasticity and narrowing o..
0
645
Alzheimer's disease is a not-so-friendly condition, it is a progressive and developing neurodegenerative disease with an insidious onset, in other wor..
0
1143
Muscular dystrophy (MD) presents a unique set of challenges to modern medicine. Chronic pain, muscle spasms and limitations in daily living and can be..
0
1130
At the end of 2022, an international multicentre, double-blind, randomised controlled efficacy and safety clinical trial involving a joint team of res..
0
1466
Causes of Hair LossHormonal Imbalance: Androgenetic alopecia is one of the most common types of hair loss, primarily linked to elevated androgen level..
0
796
It is important to note that although NMN can be supplemented through diet, the amount of NMN in food is relatively low. If supplementation with NMN i..